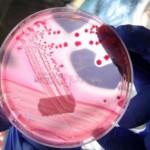
Enfeksiyona Yol Açan Kurtçuk Doğurganlığı Artırıyor

Kategori: Anneliğe Hazırlık
Kategori: Anneliğe Hazırlık

Erkek Kısırlığında Sinsi Problem Varikosel’e Dikkat!
Çocuk sahibi olma ile ilgili problemi olmayan erkeklerde de görülebilen varikosel, infertilite açısından çok daha fazla önem taşıyor. Yapılan araştırmalarda çıkan çarpıcı sonuçlara göre erkek kısırlıklarının yüzde 40’ına yakınında varikosel saptanıyor. Sessiz, sedasız bir şekilde ilerleyen varikosel erken yaşlarda çocuk sahibi olduktan sonra ilerleyen yaşla birlikte ikinci çocuk sahibi olmak isteyen erkeklerde sperm parametrelerinde bozulma […]

Gebe Kalamama Nedenleri Nelerdir?
Bazı kadınlar oldukça kolay bir şekilde hamile kalmalarına rağmen bazıları için ise gebelik aynı kolaylıkla elde edilemediğinden günümüzde çoğu kadın annelik hasreti ile yanıp tutuşuyor. Gebelik bir dizi olayın ahenk içinde işlemesi ile husule gelen bir durum olmakta ancak bir takım sağlık sorunları bu biyolojik yolculuğun engellenmesine de sebep olmaktadır. Hem kadın hem de erkekte […]

Vücut Çatlaklarına Çözüm
Her kadın gebelik döneminde çatlak problemi yaşamaktan bir hayli korkar. Gebe olunmasına rağmen vücudukorumak aslında sanıldığı kadar zor değil. Neredeyse kadınların %10′u sırf vücutları bozulacak ve çatlak problemleri meydana gelecek diye bebek sahibi olma isteklerini ertelemektedir. Gebelik döneminde alınan fazla kilolardan dolayı meydana gelen vücut çatlakları canınızı sıkmasın. Gebelik döneminde kendinizi tamamen sağlıklı beslenmeye odaklayın. Hiçbir sorunun keyfinizi […]

Tüp Bebekte Başarıyı Etkileyen Faktörler
Tüp bebek tedavisinde başarıyı etkileyen faktörlerin başında kadın yaşı ve yumurtalık rezervi geliyor. Ancak tedavide başarıyı etkileyen faktörler bununla sınırlı kalmıyor. Rahim doğuştan anormallikleri, kısırlık ve gebelik kaybı sebebine yol açan rahmin iç tabakasında ki rahatsızlıklar ve rahim içi yapışıklıkları tüp bebek tedavisinde olumsuz sonuç alınmasına büyük etki ediyor. Tüp bebek tedavisinde başarıyı etkileyen rahme […]

Yumurtlama Bozuklukları Kısırlık Nedeni mi?
Çiftlerin düzenli ilişkisine rağmen(haftada 2 kez), 1 yıl içinde çocuk sahibi olamama durumunda kısırlıktan bahsediyoruz. Kısırlık ilk kez karşımıza çıkan bir durum olabildiği gibi daha önce çocuk sahibi olmuş çiftlerin tekrar çocuk sahibi olmak istediklerinde de karşılarına çıkabilecek bir durum olabilir ve bunu sekonder infertilite olarak adlandırıyoruz. Normal çiftlerde gebelik ilk 3 ay içinde yüzde […]

Gebelik Şansını Artıran 7 Öneri
Anne-baba olmayı çok arzu ediyor ancak bir türlü mutlu sona ulaşamıyorsunuz. Çocuk hayalini gerçeğe dönüştürmek isteyen çiftlere 7 önemli öneriler 1-Anne-baba olmaya karar verildiğinde öncelikle beslenme alışkanlıkları yeniden düzenlenmelidir. Örneğin “şeker, tatlandırıcılar, kafein, sigara, kola, alkol” gibi vücuda zararlı birçok molekülün kullanımı sonlandırılmalıdır. Çay içilecekse “şekersiz” olarak ve azaltılarak içilebilir. 2-Stresten Kurtulun… Modern hayatın bir […]
Enfeksiyona Yol Açan Kurtçuk Doğurganlığı Artırıyor
Enfeksiyona yol açan bir kurtçuğun, kadınlarda doğurganlığı artırdığı görüldü. Sonuçları Science dergisinde yayınlanan araştırmada, Bolivya’da 986 yerli kadın incelendi ve “Ascaris lumbricoides” adı verilen bir tür yuvarlak kurtçuğun üreme üzerinde olumlu etkisinin olduğu keşfedildi. Bolivya’da Tsimane yerli topluluğunda bir ailenin ortalama dokuz üyesinin bulunduğu, nüfusun yüzde 70’inde “Ascaris lumbricoides” kurtçuğunun yol açtığı enfeksiyona rastlandığı belirtildi. […]

Aspirin Gebelik Şansını Arttırıyor
Aspirinin yapılan çalışmalarda kısırlık açısından gebelik şansını artıran bir ajan olduğu belirlenmiştir. Bin 128 hasta üzerinde yapılan çalışmada aspirin kullanan kişilerde gebelik şansının artırdığı yönünde çalışma sonuçlarına varılmıştır. Hem yumurtalıkların kanlanmasını hem de rahim zarının kanlanmasını artırarak, bebeğin daha iyi bir şekilde rahim zarına tutulmasını arttırmaktadır. Onun için bu çalışmada aspirin kullanımında çocuk sahibi olmak […]

Obezite Cerrahisi Hamilelik Şansını Artırıyor
Obezite girişimlerinden sonra dünyaya gelen çocuklar ile ilgili uzun süreli sonuçlarda da olumlu gelişmeler görülmektedir. Obezite için cerrahi girişim düşünülürken; hastaların, doğum uzmanlarının ve cerrahların; uzun vadeli sağlık ve iyilik hali karşılığında, cerrahi girişimin risklerini de dengelemeleri gerekiyor. Bu açılardan klinisyenlerin, her girişim için anne ve bebek yönünden risk ve faydaları değerlendirmeleri gerekiyor. Bu amaçla; […]

Bebek İçin Neler Gerekli Değil?
Yenidoğan bebeğin kafa ölçüsüne uygun giysi almak, anneliğe hazırlananların yaptığı alışveriş hatalarından biri. Yenidoğan ölçüsü sizin bebeğinize uymayabilir. Bebeğinizin boynunu zorlamak istemezsiniz. Bebek ilk doğduğunda ebeveyn odasında yatması için daha az yer kaplayan bebek sepetlerine başvurulabiliyor. Belki ilk zamanlar için kullanışlı olabilir ama bebek hızla büyüdüğünde, artık o sepet yatağa sığamamaya başladığında yapacağınız tek şey, […]


























Sosyal Medya